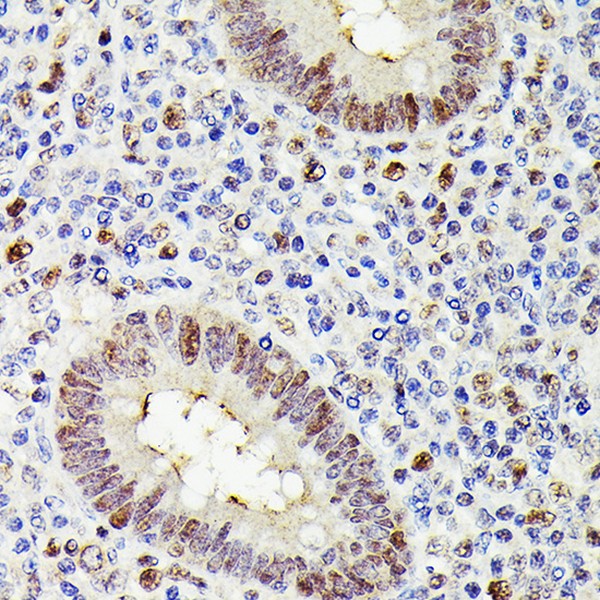
MLH1 Mouse mAb (Catalog Number: A20544) Abclonal

MLH1 Mouse mAb (A20544)
$148.00 – $548.00
Abclonal MLH1 Mouse mAb (Catalog Number: A20544) encoded by this gene can heterodimerize with mismatch repair endonuclease PMS2 to form MutL alpha, part of the DNA mismatch repair system.
- Details & Specifications
- References
| Catalog No. | A20544 |
|---|---|
| Product Name | MLH1 Mouse mAb (A20544) |
| Supplier Name | ABclonal, Inc. |
| Brand Name | Abclonal |
| Synonyms | FCC2; COCA2; HNPCC; MLH-1; hMLH1; HNPCC2; LYNCH2; MMRCS1 |
| Gene Name | MLH1 |
| Protein Name | MLH1 |
| Gene ID | 4292 |
| Clone | AMC0417 |
| Clonality | Monoclonal |
| Source/Host | Mouse |
| Reactivity | Human, Mouse |
| Conjugate | Unconjugated |
| Note | Products will be shipped from the warehouse in Massachusetts. Promotion is running from time to time. Welcome to send a request for quote to message@sydlabs.com. |
| Order Offline | Syd Labs, Inc. 4 Avenue E, Hopkinton, MA 01748 USA. Phone: 1-617-401-8149 Fax: 1-617-606-5019 Email: message@sydlabs.com |
Description
A20544: MLH1 Mouse mAb
The protein encoded by this gene can heterodimerize with mismatch repair endonuclease PMS2 to form MutL alpha, part of the DNA mismatch repair system. When MutL alpha is bound by MutS beta and some accessory proteins, the PMS2 subunit of MutL alpha introduces a single-strand break near DNA mismatches, providing an entry point for exonuclease degradation. The encoded protein is also involved in DNA damage signaling and can heterodimerize with DNA mismatch repair protein MLH3 to form MutL gamma, which is involved in meiosis. This gene was identified as a locus frequently mutated in hereditary nonpolyposis colon cancer (HNPCC).
Immunogen Information about MLH1 Mouse mAb (A20544)
Immunogen:Recombinant fusion protein containing a sequence corresponding to amino acids 1-210 of human MLH1 (NP_000240.1).
Sequence:MSFVAGVIRRLDETVVNRIAAGEVIQRPANAIKEMIENCLDAKSTSIQVIVKEGGLKLIQIQDNGTGIRKEDLDIVCERFTTSKLQSFEDLASISTYGFRGEALASISHVAHVTITTKTADGKCAYRASYSDGKLKAPPKPCAGNQGTQITVEDLFYNIATRRKALKNPSEEYGKILEVVGRYSVHNAGISFSVKKQGETVADVRTLPNA
Gene ID:4292
Swiss prot:P40692-1
Synonyms:FCC2; COCA2; HNPCC; MLH-1; hMLH1; HNPCC2; LYNCH2; MMRCS1; MLH1
Calculated MW:
Observed MW:85kDa
Images of MLH1 Mouse mAb (A20544)

Western blot analysis of lysates from Jurkat cells, using MLH1 Mouse mAb (A20544) at 1:1000 dilution.
Secondary antibody: HRP Goat Anti-Mouse IgG (H+L) (AS003) at 1:10000 dilution.
Lysates/proteins: 25ug per lane.
Blocking buffer: 3% nonfat dry milk in TBST.
Detection: ECL Basic Kit (RM00020).
Exposure time: 90s.

Western blot analysis of lysates from wild type (WT) and MLH1 knockout (KO) HeLa(KO) cells, using MLH1 Mouse mAb (A20544) at 1:1000 dilution.
Secondary antibody: HRP Goat Anti-Mouse IgG (H+L) (AS003) at 1:10000 dilution.
Lysates/proteins: 25ug per lane.
Blocking buffer: 3% nonfat dry milk in TBST.
Detection: ECL Basic Kit (RM00020).
Exposure time: 180s.

Immunohistochemistry analysis of MLH1 in paraffin-embedded human appendix using MLH1 Mouse mAb (A20544) at dilution of 1:200 (40x lens).Perform high pressure antigen retrieval with 10 mM citrate buffer pH 6.0 before commencing with IHC staining protocol.

Immunohistochemistry analysis of MLH1 in paraffin-embedded human colon carcinoma using MLH1 Mouse mAb (A20544) at dilution of 1:200 (40x lens).Perform high pressure antigen retrieval with 10 mM citrate buffer pH 6.0 before commencing with IHC staining protocol.

Immunohistochemistry analysis of MLH1 in paraffin-embedded human pancreas using MLH1 Mouse mAb (A20544) at dilution of 1:200 (40x lens).Perform high pressure antigen retrieval with 10 mM citrate buffer pH 6.0 before commencing with IHC staining protocol.
Please remember our product information: MLH1 Mouse mAb (Catalog Number: A20544) Abclonal